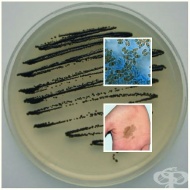

д-р Виолина Тодева
автор във Framar.bg

Д-р Тодева е специалист дерматолог, консултант на здравния портал Фрамар и част от екипа от 2010-та година, когато се сформира отдела Медицински специалисти. Участва във форума на Фрамар и дава онлайн консултации по въпроси от областта на дерматология от откриването му.
Д-р Тодева е част от екипа, разработил "Фрамар диагностик”, автор и рецензент на много статии в раздел "медицинска енциклопедия" на здравния сайт Фрамар.бг. Автор на публикации за други медицински издания и интернет сайтове.
Активно участва в различни проекти и кампании на здравна тематика:
Онлайн консултации:
Форум "Kожни и венерически болести"
Статии в интернет сайтове:
Д-р Виолина Тодева: Причина за акне след пубертет може да е хормоналният дисбаланс
Контактни дерматити при медицински персонал
Редовното хидратиране на кожата държи екземата под контрол
Периорален дерматит: причинители под прикритие
Защо не може да се отървете от акнето и къде се крие грешката за това?
Повече информация за доктор Виолина Тодева, специалист дерматолог.
Уебсайт: http://todeva.com
Профил във Facebook: https://www.facebook.com/dr.violina.todeva/
Публикации на автора

B08.2 Внезапна екзантема (шеста болест)

B08.8 Други уточнени вирусни инфекции, характеризиращи се с увреждане на кожата и лигавиците

B09 Вирусна инфекция, характеризираща се с увреждане на кожата и лигавиците, неуточнена

B08 Други вирусни инфекции, характеризиращи се с увреждания на кожата и лигавиците, некласифицирани другаде


B00.1 Херпес-вирусен везикуларен дерматит

B00.9 Херпес-вирусна инфекция, неуточнена


B47 Мицетом

B36.0 Разноцветен лишей
B36.1 Черна микоза

Коментари към д-р Виолина Тодева
Deyana Deyancheva
Здравейте, От около седмица имам болезнени, възпалени пъпки с бяло гнойно съдържание около брадичката и под нея. Използвам Фуцидин крем (2 пъти дневно) вече 6 дни, както и хидратиращ крем + слънцезащитен през деня, вечер използвам нежна измиване пяна с 5.5ph, но не забелязвам особено подобрение. Пъпките са чувствителни при допир, част от тях са дълбоки, кожата е зачервена. Не съм ги изстисквала. Имам чувствителна към мазна кожа. Цикълът ми е редовен и нямам установени здравословни проблеми. Моля за съвет относно терапия или нужда от допълнително лечение – дали Фуцидин е подходящ и какво бихте препоръчали като следваща стъпка? Благодаря предварително!
Здравейте! Това не е платформа за връзка с лекари, а информационна страница. Посетете лекар за оценка на състоянието и подходяща терапия.
Здравейте, От около седмица имам болезнени, възпалени пъпки с бяло гнойно съдържание около брадичката и под нея. Използвам Фуцидин крем (2 пъти дневно) вече 6 дни, както и хидратиращ крем + слънцезащитен през деня, вечер използвам нежна измиване пяна с 5.5ph, но не забелязвам особено подобрение. Пъпките са чувствителни при допир, част от тях са дълбоки, кожата е зачервена. Не съм ги изстисквала. Имам чувствителна към мазна кожа. Цикълът ми е редовен и нямам установени здравословни проблеми. Моля за съвет относно терапия или нужда от допълнително лечение – дали Фуцидин е подходящ и какво бихте препоръчали като следваща стъпка? Благодаря предварително!
Gabi
Преди около седмица ми се появи гъбична инфекция, моята гинеколожка ми изписа Микомакс 150 и Гиназол. Микомакса трябваше да го приема аз и моят съпруг еднократно. Но от днес по пениса на съпруга ми се появиха като ситни бели пъпчици и леко зачервяване. Въпроса ми е с какво може да се маже за да се оправи. За момента за преглед ни е малко сложно да дойдем! Благодаря предварително!
Здравейте! Това е информационна страница, а не платформа за връзка с д-р Тодева. Необходимо е да се консултирате с лекар.
Преди около седмица ми се появи гъбична инфекция, моята гинеколожка ми изписа Микомакс 150 и Гиназол. Микомакса трябваше да го приема аз и моят съпруг еднократно. Но от днес по пениса на съпруга ми се появиха като ситни бели пъпчици и леко зачервяване. Въпроса ми е с какво може да се маже за да се оправи. За момента за преглед ни е малко сложно да дойдем! Благодаря предварително!
Деница Михайлова
Здравейте! Имам бебе на 6 месеца. Преди няколко седмици му се появиха на лицето кожни зачервявания. Моля за съвет.
Здравейте! Това е информационна страница. Може да се консултирате с д-р Тодева във форума на Фрамар в тази тема: Кожни проблеми бебета и деца онлайн консултация с дерматолог
Здравейте! Имам бебе на 6 месеца. Преди няколко седмици му се появиха на лицето кожни зачервявания. Моля за съвет.
Blagodarq
Meri
Imam bebe na 1 godina i 4 meseca i ima pampers dermatit izpolzvah ekzoderil rastvor na pioktanin pove4eto se mahna no ima oshte kakvo bihte me posavetvali
Здравейте! Това е информационна страница. Консултация с д-р Тодева може да проведете във форума на Фрамар в тази тема: Кожни проблеми бебета и деца онлайн консултация с дерматолог
Fatme
Zdraveite blagodarq za statiite kak1v shampoan da izpolzvam za otmivane na maskite. Izbrah tazi s bira med i banan.
Може да използвате шампоана срещу косопад, например: ДЮКРЕ АНАФАЗ ШАМПОАН ПРОТИВ КОСОПАД 200 мл.
Imam bebe na 1 godina i 4 meseca i ima pampers dermatit izpolzvah ekzoderil rastvor na pioktanin pove4eto se mahna no ima oshte kakvo bihte me posavetvali